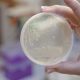

Станом на сьогодні на території України циркулює щонайменше 10 різних підтипів коронавірусу, зокрема і штам FLiRT, який був зареєстрований вперше в світі в березні цього року. В країні за останній місяць зросла кількість захворювань, але поки що нема прогнозів про можливість епідемії. Про це Суспільному розповів заступник міністра охорони здоровʼя, головний санітарний лікар України Ігор Кузін.
«Поширення нового штаму збігається з загальносвітовою тенденцією. SARS-CoV-2 постійно мутує. Станом на зараз на території України циркулює щонайменше 10 різних підтипів або субваріантів штамового мікрофту. Всі ці штами мають різну характеристику. І останній з тих, який був ідентифікований на території України, є штам FLiRT, який був зареєстрований вперше в світі в березні цього року», — сказав він.
Головний санлікар зазначив, що Сполучені Штати повідомили про те, що в середньому на 20% в них зросла захворюваність. Приблизно такі ж самі показники реєструється і в Великій Британії.
За словами Кузіна, FLiRT має певні особливості.
«У людей, які мають проблеми з імунітетом, імуноскомпрометований стан або супутні захворювання неінфекційної природи, вони більш схильні до захворювання і навіть до повторного захворювання ковідом. Людина, яка не має повного курсу щеплень, також більш схильна до того, щоб знову захворіти ковідом», — сказав урядовець.
Він зазначив, що поки що нема повідомлень про те, що новий штам протікає або надто небезпечно, або викликає якісь важкі ускладнення або тяжкий тип захворювання.
«Станом на сьогодні симптоми залишаються такі ж самі. Єдиною типовою характеристикою є те, що на початку захворювання значне підвищення температури, яка достатньо важко збивається, але випадки найчастіше проходять без виникнення пневмонії», — сказав Кузін.
Головний санлікар зазначив, що вакцина залишається ефективною, тому що зараз в країні використовується Омікрон-спеціфічна вакцина, яка активна до всього типу штаму Омікрон, незалежно від того, які підтипи або субваріанти циркулюють.
Джерело: УНН
.